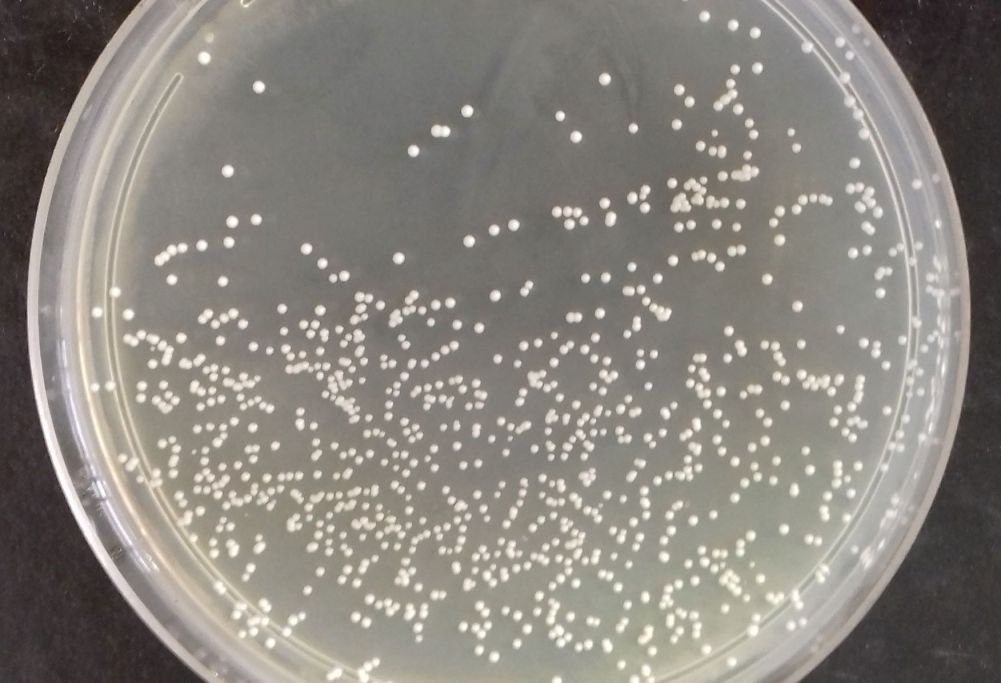
Seu intestino pede ajuda? Entenda como escolher um probiótico

Diarreia persistente, constipação, gases, inchaço e desconforto abdominal são sinais de que algo não vai bem no seu intestino. Esses sintomas, cada vez mais comuns em pessoas com rotinas alimentares irregulares, apontam para um possível desequilíbrio da microbiota intestinal e, nesse cenário, os probióticos surgem como aliados. Mas é preciso cuidado: a escolha não deve ser feita no impulso ou apenas com base em recomendações genéricas.
Probióticos são microrganismos vivos que, quando ingeridos em quantidades adequadas, conferem benefícios à saúde. Mas sua eficácia depende da indicação correta, conforme explicam especialistas. “O uso rotineiro sem uma avaliação específica não é recomendado”, alerta Louise Deluiz Verdolin Di Palma, gastroenterologista do Hospital Samaritano Barra, no Rio de Janeiro.
Nem todos os probióticos são iguais. Cada cepa atua de forma diferente no organismo e, por isso, deve ser prescrita de forma individualizada, com base nos sintomas de cada paciente. “Muitas pessoas acham que é só ir à farmácia e pegar qualquer caixa. Isso é um erro”, afirma Di Palma.
Cada queixa exige uma cepa diferente
Quando há um desequilíbrio na flora intestinal –o que os médicos chamam de disbiose–, é comum o paciente apresentar sintomas como diarreia, prisão de ventre, gases e dor abdominal. Nessas situações, os probióticos podem ser úteis, mas apenas se forem escolhidos de forma adequada. “Existem guidelines médicos com indicações específicas de cepas conforme o problema”, explica Di Palma.
A médica exemplifica: para constipação, são usados o Bifidobacterium lactis e o Lactobacillus acidophilus. Já para diarreia e recuperação após uso de antibióticos, o ideal é optar pelo Saccharomyces boulardii ou o Lactobacillus rhamnosus GG, que ajudam a restaurar a microbiota e a reduzir o tempo de sintomas.
Izabela Guimarães Dias Cavalcante, nutricionista do CEPARH e especialista em nutrição clínica, reforça que a seleção das cepas deve ser feita com base na queixa principal. “É preciso ter uma avaliação prévia de um profissional capacitado, que vai definir a combinação certa e a dose necessária”, diz.
Cápsula ou sachê?
A forma de apresentação do probiótico também interfere na eficácia. Segundo Di Palma, tanto cápsulas quanto sachês utilizam técnicas para proteger as bactérias da acidez do estômago. No entanto, estudos apontam que cápsulas de liberação retardada tendem a garantir maior taxa de sobrevivência das cepas até o intestino.
Cavalcante destaca que a cápsula vegetal é a opção mais estável. “Ela garante que as cepas cheguem íntegras ao intestino e controla melhor a umidade”, afirma. Mas reconhece que o sachê pode ser mais viável para crianças e idosos com dificuldade de deglutição, embora sua estabilidade seja menor.
Outro cuidado importante: alguns probióticos em sachê precisam ser dissolvidos em alimentos frios. Se forem misturados a líquidos ou comidas quentes, sua eficácia pode ser comprometida.
Iogurte, kefir e outras bebidas fermentadas podem até ser saudáveis, mas não devem ser confundidas com probióticos. “Alimentos fermentáveis passam por fermentação por bactérias ou leveduras, mas não necessariamente têm quantidade suficiente de microrganismos vivos para serem considerados probióticos”, explica Di Palma.
A nutricionista concorda: “Essas bebidas têm pouquíssimos lactobacilos vivos, além de conterem muito açúcar”. Ela recomenda que esses alimentos sejam usados como complemento de uma dieta equilibrada, mas não como substitutos dos suplementos probióticos prescritos.
Além dos probióticos, há os prebióticos, fibras e compostos não digeríveis que servem de alimento para as bactérias benéficas do intestino. “Alimentos como cebola, banana, alho, raiz de chicória e alho-poró são ricos em prebióticos”, orienta Di Palma.
Já os simbióticos são a combinação dos dois: probióticos + prebióticos. “Eles potencializam os benefícios, pois além de inserirmos as bactérias boas, também fornecemos o alimento ideal para que elas se desenvolvam”, explica Cavalcante.
Contraindicações e efeitos na saúde mental
Embora seguros para a maioria das pessoas, os probióticos devem ser evitados por grupos específicos. “Neonatos prematuros e pessoas imunocomprometidas correm maior risco de infecções, ainda que raras, devido à presença de microrganismos vivos”, adverte Di Palma. Por isso, a orientação médica é fundamental.
Estudos também sugerem uma relação promissora entre o uso de probióticos e benefícios à saúde mental. “Há cepas que atuam no eixo intestino-cérebro, influenciando neurotransmissores como a serotonina”, explica a gastroenterologista. Uma das cepas citadas por ela é a Lacticaseibacillus rhamnosus KY16, que demonstrou impacto positivo em casos de depressão. Outra, a Lactobacillus plantarum 286, foi associada à redução de ansiedade em modelos animais.
Cavalcante acrescenta que há indícios de que essas cepas também reduzem marcadores inflamatórios em transtornos como depressão, TDA e transtorno bipolar, podendo ser incluídas como tratamento complementar. “Mas sempre com acompanhamento médico e nutricional”, ressalta.
A base de tudo ainda é o estilo de vida
Mesmo com todas essas alternativas, especialistas são unânimes em afirmar que a alimentação equilibrada é o principal caminho para a saúde intestinal. “Uma dieta rica em fibras, frutas, vegetais, grãos integrais e alimentos fermentados já promove um bom equilíbrio da microbiota”, destaca Di Palma.
Cavalcante complementa que o efeito é potencializado com atividade física regular e sono de qualidade. “A suplementação só entra quando, mesmo com esses cuidados, a pessoa continua com sintomas”, diz.
Ou seja: antes de comprar um probiótico na farmácia, o melhor caminho é procurar orientação profissional. Afinal, escolher o produto errado pode ser ineficaz e até desperdiçar uma chance de melhorar sua saúde intestinal e muito além dela.
Fonte: https://www.cnnbrasil.com.br/saude/seu-intestino-pede-ajuda-entenda-como-escolher-um-probiotico/